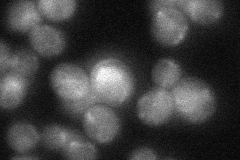

View description
Mitochondrial malate dehydrogenase, catalyzes interconversion of malate and oxaloacetate; involved in the tricarboxylic acid (TCA) cycle; phosphorylated
Localization:
Intensity:
Fold change:
Significance:
-
C’ GFP library in SD

mitochondria257.7 -
N' NOP1pr-GFP in SD

mitochondria107.098 -
N' TEF2pr-mCherry in SD

punctate,mitochondria43.3417 -
N' NATIVEpr-GFP in SD
cytosol,mitochondria34.1161 -
N' TEF2pr-VC and Cyto-VN in SD

#N/A0 -
C’ GFP library in SD+DTT

mitochondria362.021.4No -
C’ GFP library in SD+H2O2

mitochondria241.920.93No -
C’ GFP library in Starvation Media

mitochondria317.781.23No -
C’ GFP library on the background of Pup2-DaMP

mitochondria -
C’ GFP library on the background of CCT mutant

mitochondria263.2111.02133No
